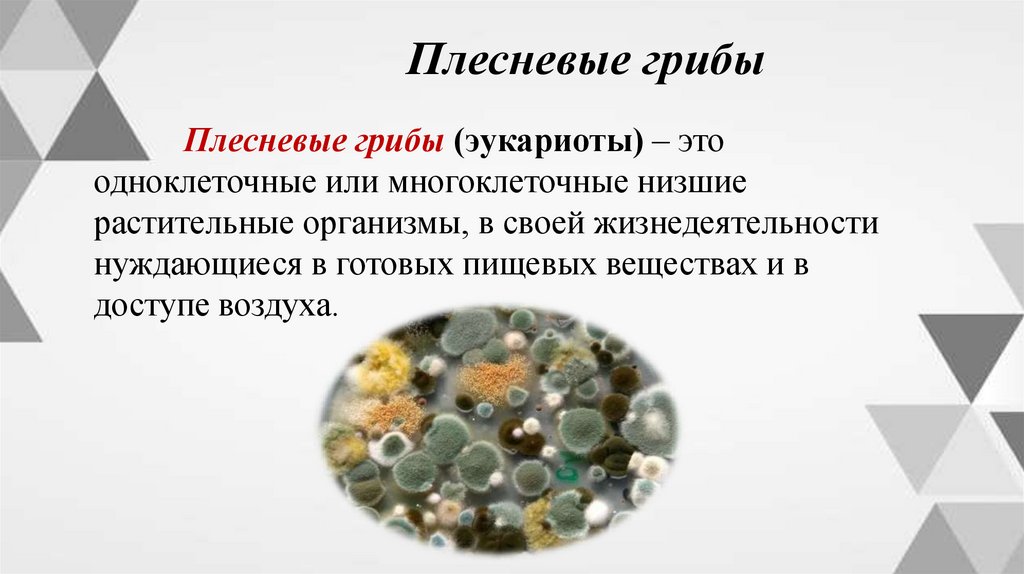

Similar presentations:
Морфология микробов
1. Тема урока Морфология микробов
2. Что такое морфология?
Морфология — это изучение строения.В это понятие входят форма, размер, структура
клетки, подвижность (возможность двигаться в
жидкой среде), спорообразование.
3. Классификация микроорганизмов
4.
Дорожная карта урока1. Строение бактерий
2. Строение грибов
3. Строение дрожжей
4. Строение вирусов
5.
БактерииБактерии (прокариоты) –
большая группа микроорганизмов,
включает более 4000 видов,
большинство из них одноклеточные.
Размеры и форма бактерий могут
изменяться в зависимости от
различных факторов внешней среды.
Способ размножения – простое
деление.
6.
БактерииВ бактериальной клетке различают оболочку,
цитоплазму и ядерное вещество.
На поверхности некоторых бактерий есть жгутики
(нитевидные образования), с помощью которых бактерии
передвигаются.
7.
БактерииОболочка бактерий состоит из азотистых
веществ, углеводов и липидов. Отличается большой
прочностью. В ней различают два слоя: наружный
(клеточная стенка) – придает форму и
цитоплазматическая мембрана – заключает в себе
ферментные системы.
Цитоплазма – прозрачная, студенистая масса.
Резервный питательный материал.
Ядерное вещество – хранит ДНК и РНК.
8.
БактерииПо строению клеточной стенки различают
грамположительные и грамотрицательные
бактерии.
Грамположительные бактерии имеют синефиолетовый окрас.
Грамотрицательные бактерии имеют красный окрас.
9.
Формы бактерийМикрококки – это род
маленьких грамположительных сферических бактерий.
10.
Формы бактерийСтрептококки – это род шаровидных
грамположительных бактерий.
11.
Формы бактерийСарцины – род грамположительных кокков,
делящихся в трех взаимно перпендикулярных
направлениях, образуя при этом кубические «тюки».
12.
Формы бактерийПалочки без спор грамположительные палочки неправильной формы,
растущие в присутствии воздуха.
13.
Формы бактерийПалочки со спорами (бациллы) палочковидные бактерии, образующие
внутриклеточные споры.
14.
Формы бактерийВибрионы - грамотрицательные, изогнутые в виде
запятой палочки.
15.
Формы бактерийСпирохеты - это спиралевидная бактерия, которая
обитает на слизистых оболочках верхних дыхательных
путей человека.
16.
Формы бактерийСпириллы - род бактерий, имеющих форму
спирально извитых или дугообразно изогнутых
палочек.
17.
Формы бактерийТетракокки — тип шаровидных бактерий, клетки
которых делятся в двух взаимно перпендикулярных
плоскостях и не расходятся после деления.
18.
Плесневые грибыПлесневые грибы (эукариоты) – это
одноклеточные или многоклеточные низшие
растительные организмы, в своей жизнедеятельности
нуждающиеся в готовых пищевых веществах и в
доступе воздуха.
19.
Плесневые грибыКлетки плесневых грибов имеют форму вытянутых
переплетающихся нитей, которые называются гифами.
Они образуют тело плесени – мицелий (грибницу).
На поверхности мицелия развиваются плодовые тела, в
которых созревают споры.
20.
Плесневые грибыПлесневые грибы размножаются в основном
двумя способами: бесполым (вегетативно) и
половым.
Развиваются грибы на продуктах питания, их
можно обнаружить в виде налета (плесени), на
гниющих остатках растений.
21.
Плесневые грибыПлесневый гриб мукор – поражает хлеб,
кондитерские изделия и грибы.
Плесневый гриб аспергилл – поражает мучные
изделия и другие продукты.
Плесневый гриб фузариум - поражает
пшеницу и кукурузу.
22.
ДрожжиДрожжи (эукариот) – это одноклеточные
неподвижные микроорганизмы (грибы). Они бывают
круглой, овальной и палочковидной формы.
23.
ДрожжиДрожжи развиваются двумя способами:
бесполым (почкование) или половым
(спорообразование).
Дрожжи культурные используются человеком в
производстве вина, спирта, хлеба, пива и тд. Дикие
дрожжи не характерны для пищевого производства, но
попадают туда случайно и снижают активность
культурных дрожжей.
24.
ВирусыВирус (лат. virus - яд) - инфекционный агент,
который может воспроизводиться только внутри
живых клеток организма. Не имеет клеточного
строения.
Вирусы не способны размножаться во внешней
среде. Они стойки к высушиванию, низкой
температуре, но малоустойчивы к воздействию
высокой температуры, ультрафиолетовых лучей и
радиаций.

biology
biology








